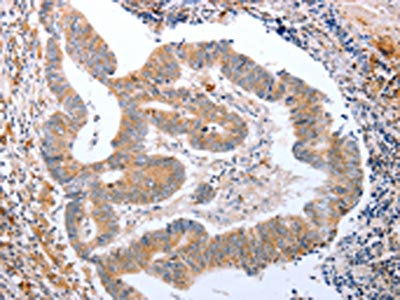

CDK20 Antibody
-
中文名稱:CDK20兔多克隆抗體
-
貨號(hào):CSB-PA578796
-
規(guī)格:¥1100
-
圖片:
-
The image on the left is immunohistochemistry of paraffin-embedded Human colon cancer tissue using CSB-PA578796(CDK20 Antibody) at dilution 1/15, on the right is treated with fusion protein. (Original magnification: ×200)
-
The image on the left is immunohistochemistry of paraffin-embedded Human ovarian cancer tissue using CSB-PA578796(CDK20 Antibody) at dilution 1/15, on the right is treated with fusion protein. (Original magnification: ×200)
-
Gel: 8%SDS-PAGE, Lysate: 40 μg, Lane: HT29 cells, Primary antibody: CSB-PA578796(CDK20 Antibody) at dilution 1/300, Secondary antibody: Goat anti rabbit IgG at 1/8000 dilution, Exposure time: 5 minutes
-
-
其他:
產(chǎn)品詳情
-
Uniprot No.:
-
基因名:CDK20
-
別名:CAK kinase p42 antibody; CAK-kinase p42 antibody; CCRK antibody; CDCH antibody; CDK activating kinase p42 antibody; CDK-activating kinase p42 antibody; cdk20 antibody; CDK20_HUMAN antibody; Cell cycle related kinase antibody; Cell cycle-related kinase antibody; Cell division protein kinase 20 antibody; Cyclin dependent protein kinase H antibody; Cyclin kinase activating kinase p42 antibody; Cyclin-dependent kinase 20 antibody; Cyclin-dependent protein kinase H antibody; Cyclin-kinase-activating kinase p42 antibody; p42 antibody; PNQALRE antibody
-
宿主:Rabbit
-
反應(yīng)種屬:Human,Mouse,Rat
-
免疫原:Fusion protein of Human CDK20
-
免疫原種屬:Homo sapiens (Human)
-
標(biāo)記方式:Non-conjugated
-
抗體亞型:IgG
-
純化方式:Antigen affinity purification
-
濃度:It differs from different batches. Please contact us to confirm it.
-
保存緩沖液:-20°C, pH7.4 PBS, 0.05% NaN3, 40% Glycerol
-
產(chǎn)品提供形式:Liquid
-
應(yīng)用范圍:ELISA,WB,IHC
-
推薦稀釋比:
Application Recommended Dilution ELISA 1:1000-1:2000 WB 1:200-1:1000 IHC 1:25-1:100 -
Protocols:
-
儲(chǔ)存條件:Upon receipt, store at -20°C or -80°C. Avoid repeated freeze.
-
貨期:Basically, we can dispatch the products out in 1-3 working days after receiving your orders. Delivery time maybe differs from different purchasing way or location, please kindly consult your local distributors for specific delivery time.
-
用途:For Research Use Only. Not for use in diagnostic or therapeutic procedures.
相關(guān)產(chǎn)品
靶點(diǎn)詳情
-
功能:Required for high-level Shh responses in the developing neural tube. Together with TBC1D32, controls the structure of the primary cilium by coordinating assembly of the ciliary membrane and axoneme, allowing GLI2 to be properly activated in response to SHH signaling. Involved in cell growth. Activates CDK2, a kinase involved in the control of the cell cycle, by phosphorylating residue 'Thr-160'.
-
基因功能參考文獻(xiàn):
- Results delineate an immunosuppressive mechanism of the hepatoma-intrinsic CCRK signalling and highlight an overexpressed kinase target whose inhibition might empower hepatocellular carcinoma immunotherapy PMID: 28939663
- A CCRK-EZH2 epigenetic circuitry drives hepatocarcinogenesis and associates with tumor recurrence and poor survival of patient. PMID: 25500144
- Data indicate that expression of ERAS, LHX1, and CCRK is increased in aggressive subgroups of medulloblastomas. PMID: 22875024
- Cell cycle-related kinase is a direct androgen receptor-regulated gene that drives beta-catenin/T cell factor-dependent hepatocarcinogenesis PMID: 21747169
- results suggest for the first time that CCRK is involved in colorectal cancer carcinogenesis and G1/S cell cycle transition by regulating Cdk2, cyclin E and Rb. PMID: 20466538
- identification of p42, a novel cyclin-dependent kinase-activating kinase (CAK) activity in human cells; p42 is essential for the phosphorylation of Thr-160 and activation of CDK2 and is indispensable for cell growth PMID: 14597612
- Depletion of PNQALRE by >80% due to RNA interference (RNAi) impairs cell proliferation, but fails to arrest the cell cycle at a discrete point. PMID: 16552187
- Overexpression of CCRK is associated with ovarian carcinoma. PMID: 19672860
顯示更多
收起更多
-
亞細(xì)胞定位:Nucleus. Cytoplasm. Cell projection, cilium.
-
蛋白家族:Protein kinase superfamily, CMGC Ser/Thr protein kinase family, CDC2/CDKX subfamily
-
數(shù)據(jù)庫(kù)鏈接:
Most popular with customers
-
-
YWHAB Recombinant Monoclonal Antibody
Applications: ELISA, WB, IHC, IF, FC
Species Reactivity: Human, Mouse, Rat
-
Phospho-YAP1 (S127) Recombinant Monoclonal Antibody
Applications: ELISA, WB, IHC
Species Reactivity: Human
-
-
-
-
-